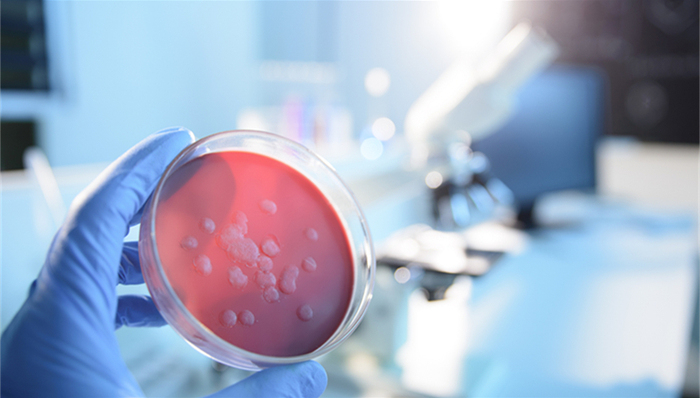
热点关注

记者 | 牛其昌
中国农科院兰州兽医研究所多位师生在布鲁菌病的检测中,发现抗体呈阳性,引发广泛关注。
2019年12月6日下午,兰州市疾病控制预防中心相关负责人对界面新闻记者证实,确有此事,前期已经对相关情况进行调查,并提供了相应的技术支持,具体调查进展以官方通报为准。
此前有网友在知乎爆料称,“2019年12月5日兰州兽医研究所被曝近百名学生布病感染血清型阳性”,首次发现“感染”者是11月中旬左右。到11月24日,有8个左右的血清阳性患者,基本都是实验室的人。
12月6日晚,中国农科院兰州兽医研究所微信公号发布通报称,11月28-29日,中国农业科学院兰州兽医研究所口蹄疫防控技术团队先后报告有4名学生布鲁氏菌病血清学阳性。接到报告后,兰州兽医研究所立即派人陪同学生前往医院诊治,同时成立调查小组,关闭相关实验室并开展调查。
据悉,截至目前共检测263人份,经甘肃省疾控中心确认呈现血清学阳性65人。血清学阳性人员中个别人员自感有身体不适现象,其余人员未出现明显临床症状。

12月5日,据甘肃省疾控中心官网发布的资料显示,布鲁氏菌病(下称布病)是一种由布鲁氏菌引起的严重危害人民健康和畜牧业发展的人畜共患传染病,是《中华人民共和国传染病防治法》规定的乙类传染病,群众称之为蔫巴病、懒汉病。
人类对布氏菌属中的大多数细菌都是易感的。我国目前将布病列入了乙类传染病。染疫的家畜是人间布病的主要传染源,人由于接触患病的牲畜及其产品或其污染物而感染布病。据悉,甘肃省是我国五大畜牧省份之一,同时也是历史上布病流行较为严重的省份之一,全省14个市(州)86个县(市)、区曾有不同程度的暴发和流行。
在传染源方面,已知有60多种动物可作为布氏菌贮存宿主。羊、牛、猪作为传染源最为常见。其中羊是人类布病的最主要传染源。除了病羊、牛、猪外,其他患病动物也可作为人类布病的传染源,但一般只引起个别病例。人与人之间不会传播。布病传播途径主要有直接接触、消化道和呼吸道传播3种。
在临床症状方面,布氏菌可侵犯人体的网状内皮系统,引起多系统多器官损害。潜伏期一般为1—3周,平均为2周,部分病例潜伏期会更长。急性期病例以发热、乏力、多汗、肌肉关节疼痛和肝、脾、淋巴结肿大为主要表现。慢性期病例多表现为关节损害、长期发热等等。资料显示,布病病程长短不一,以3-12个月者居多,多数患者只要及时就医,规范治疗,一般预后良好。患者如不及时治疗,易由急性转成慢性,反复发作。
兰州兽医研究所方面表示,事件发生后,中国农业科学院第一时间启动应急处置预案,派工作组赴兰州指导和督促兰州兽医研究所做好应急处置等相关工作。国家卫生健康委员会、国家疾控中心、甘肃省疾控中心、甘肃省兽医局、兰州市卫生健康委、兰州市疾控中心、城关区和七里河区疾控中心等多部门组成联合工作组,设立流行病学调查组、治疗专家组,到兰州兽医研究所开展流行病学调查,协调诊断治疗。目前正在采取多项措施治疗人员。
通报称,在首例阳性发生后,11月29日研究所组织学生进行诊治。阳性报告数量增加后,在甘肃省卫生健康委和兰州市卫生健康委及疾控中心的协调下,邀请相关专家研究制定了治疗方案,确定诊治医院,并开辟绿色救治通道,对学生进行检查、诊治。
收到报告后,研究所封闭相关实验室、实验动物、动物舍,配合流行病学调查组调查40多人,配合调查组对动物房饲养实验动物实验室进行了取样,对阳性人员用餐餐厅、研究所周边饭馆进行调查。目前,具体的疫源调查工作正在进行。有新情况该所将及时发布。

评论